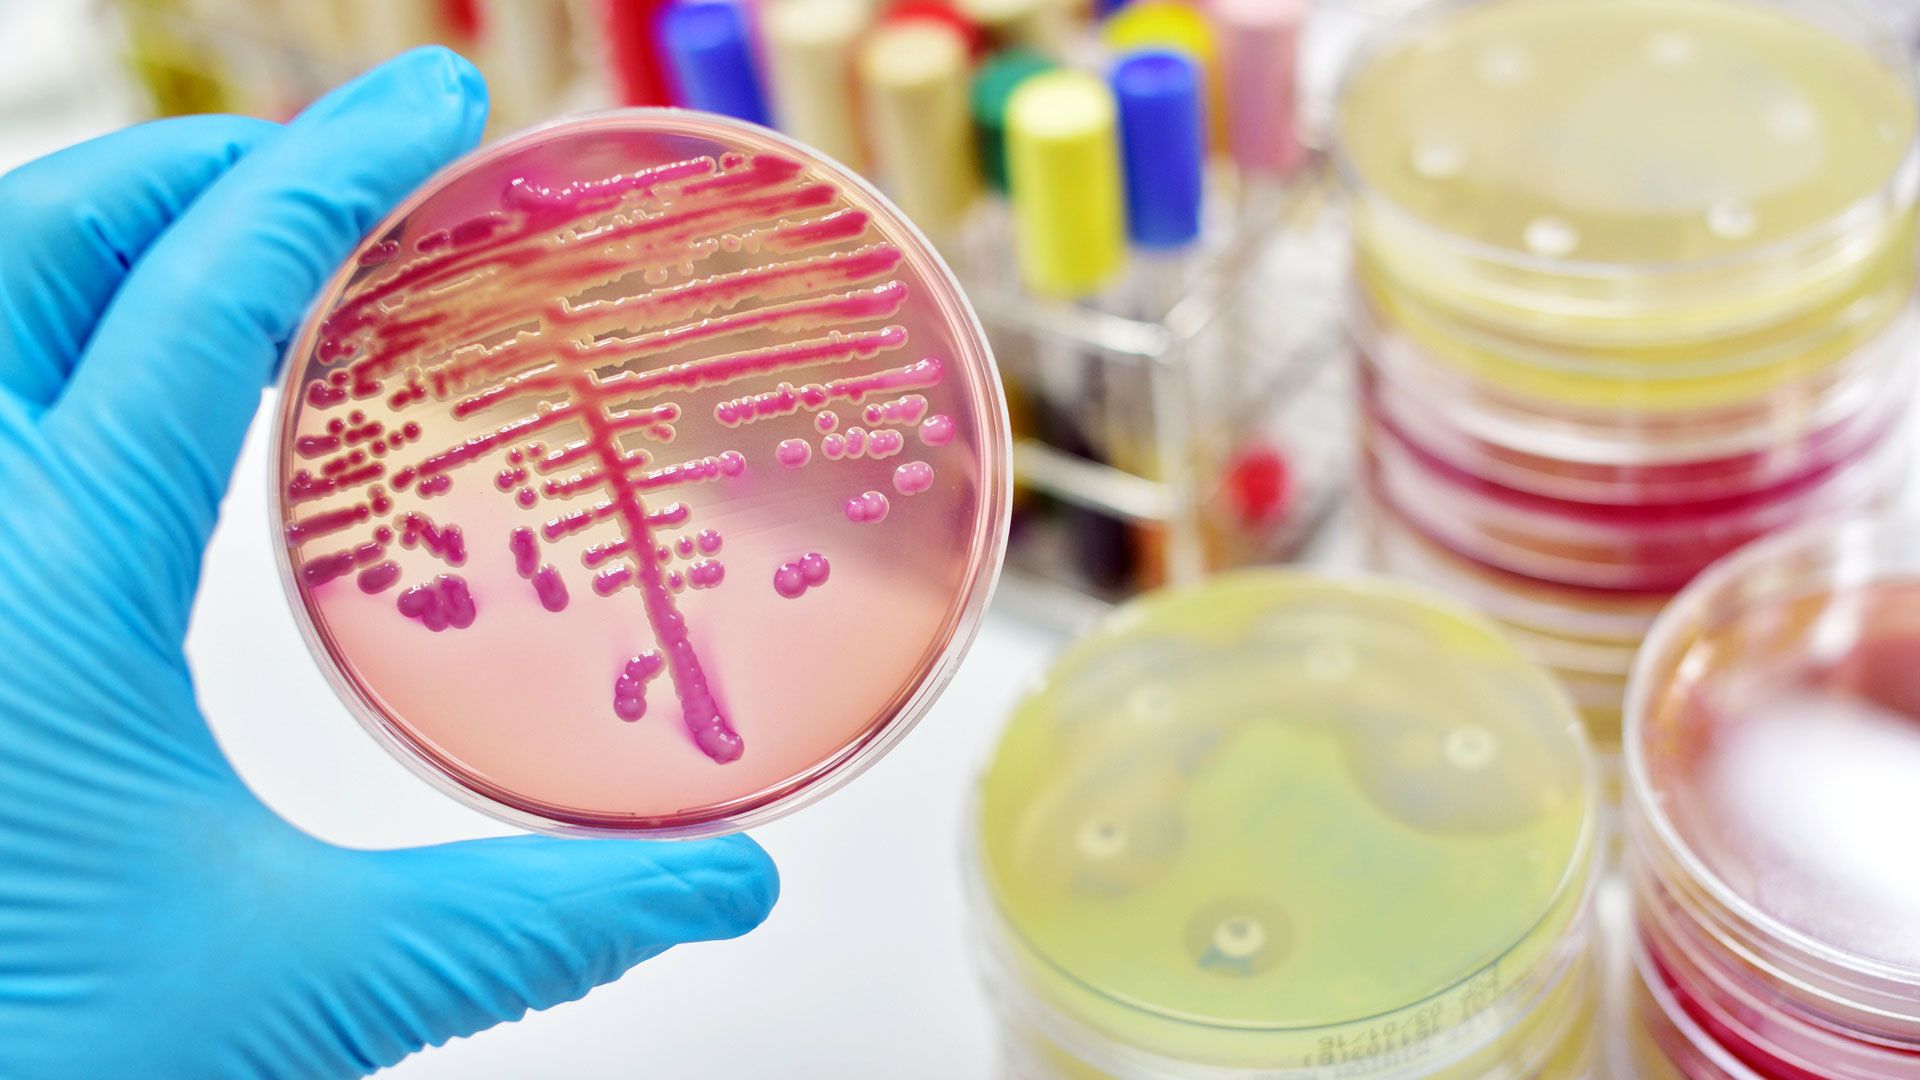

Népművészet és havas hegyek a petricsészében: szavazz a magyarokra!

Mit tudnak az asztrofizikusok a divatról?

Tudtad, hogy a Dirty Dancingből és Dallasból is készült videójáték?

Videó: a terepjárózás nem csak a férfiaké!

Sorozatfüggők figyelmébe: érdekes újítást próbálgat a Netflix

Jön a november, erre figyelj nagyon, ha autóba ülsz!

Az ISIS-vezér halála után ez az ember léphet az örökébe

Be mernél menni a világ legparább szabadulószobájába?

Milliókért adhatod bérbe az arcodat

Akár hiszed, akár nem, a bálnatrágya rád is hatással van!

Az E-számoktól nem félni kell, értünk vannak, nem ellenünk

A genetikai hátterű betegségek többségét kijavíthatja egy új módszer

Ha eddig nem féltél a kamuvideóktól, most majd fogsz

Ma Magyarországon melegnek lenni „káros a fiatalok erkölcsi fejlődésére”

A bőrödet használhatja képernyőnek a következő okosórád

„A nők is lehetnek sikeresek a technológiában, és a férfiak is a divatban”

Nem csak Greta Thunbergé a világ: ismerd meg ezeket a fiatal klímaaktivistákat is!

Te nevezheted el a Szaturnusz új holdjait

Felejtsd el az esszenciális olajokat, nem sok hatásuk van!

KIA Sorento teszt: intelligens hétüléses

Székely Dorottya: „Egy falunyi ember dolgozott a magyar Netflixért”

Bíró Zsófia: „Azért mesét írtam, mert a mesékben lehet rendszerszintű változásokról beszélni”

Már most érdemes beadatni az influenzaoltást



